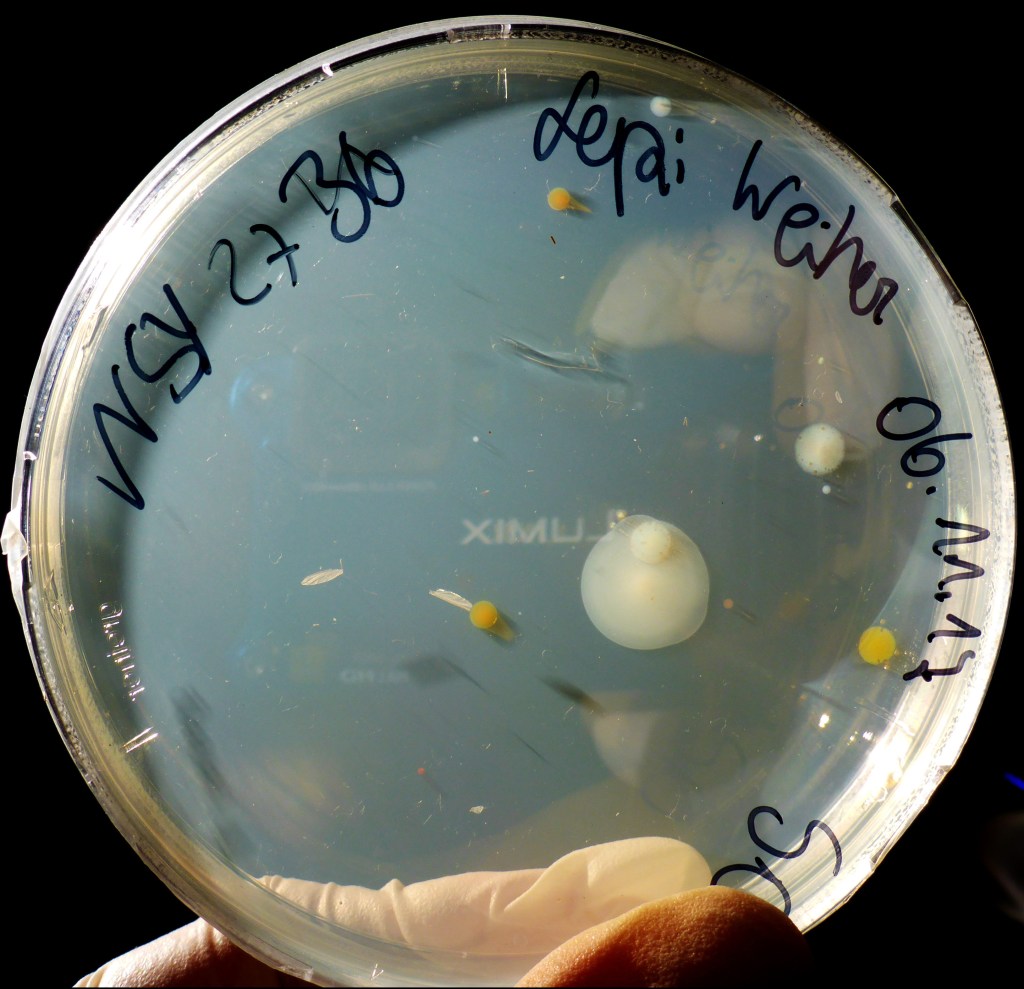
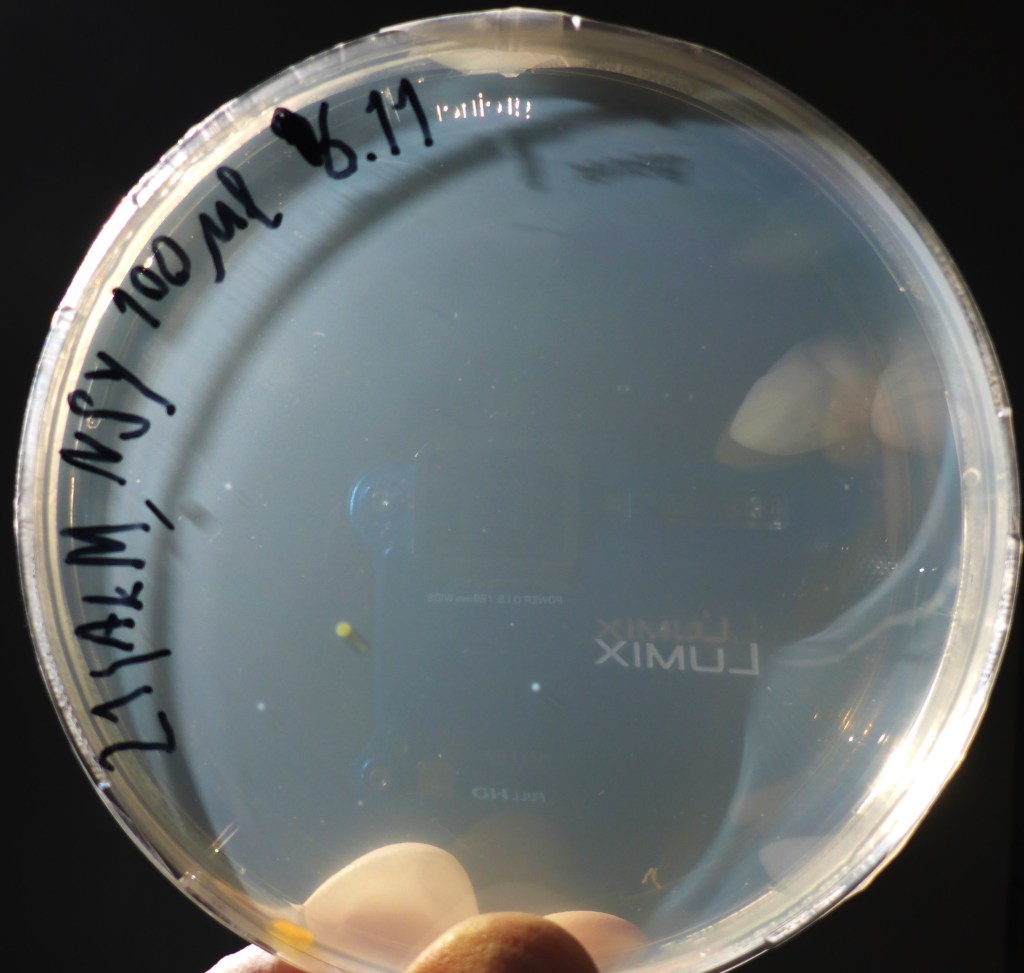
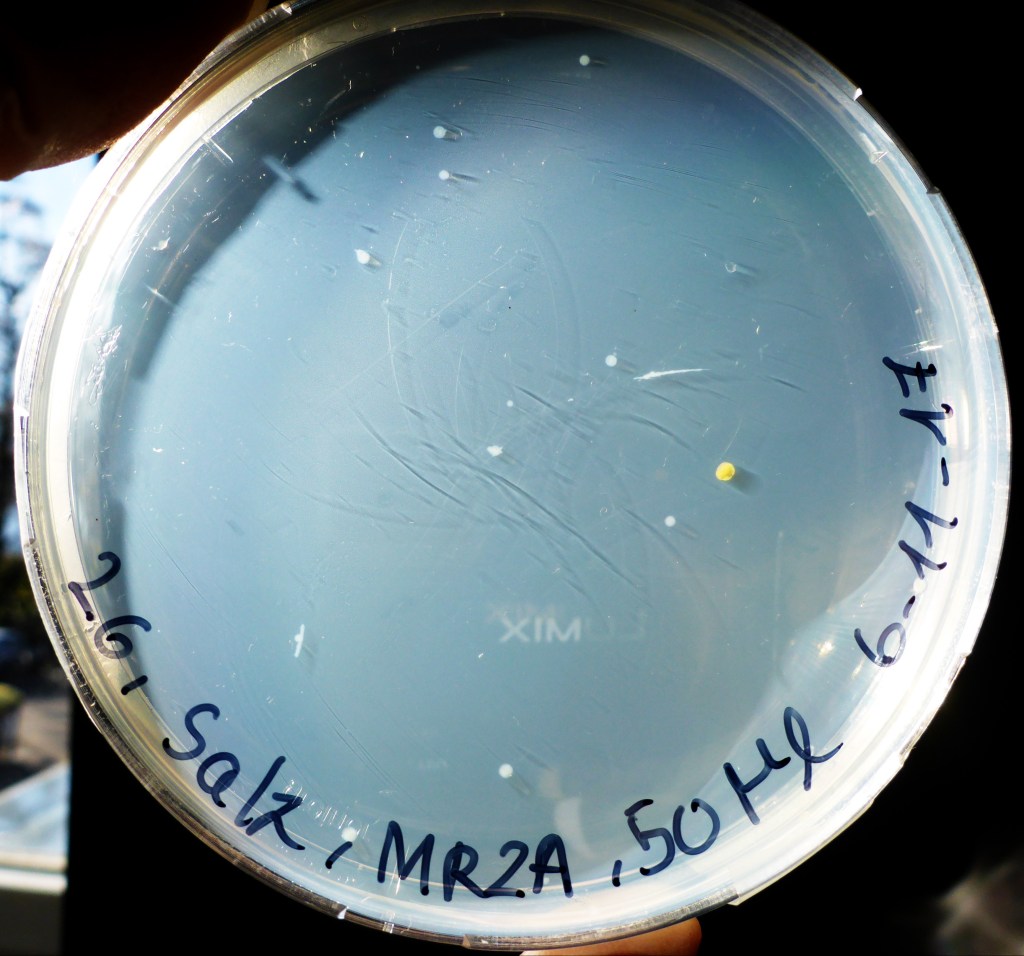
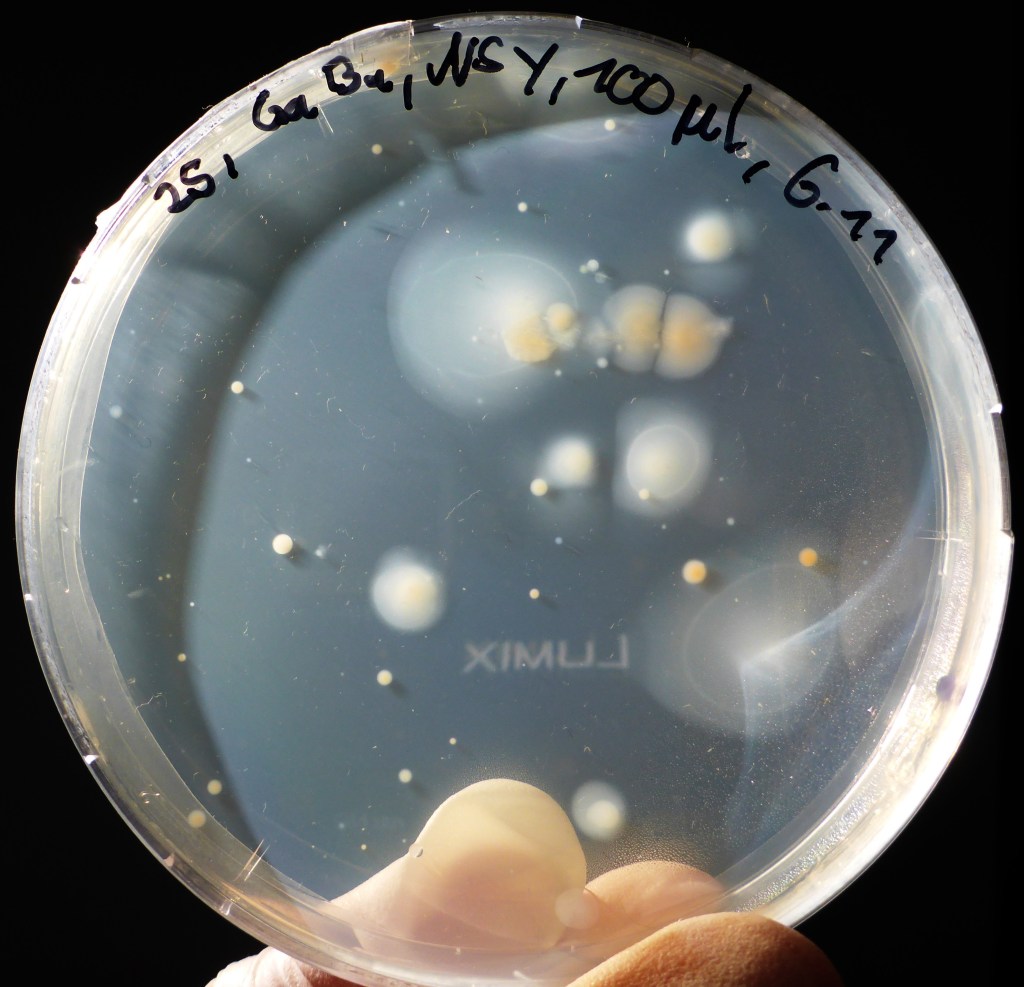
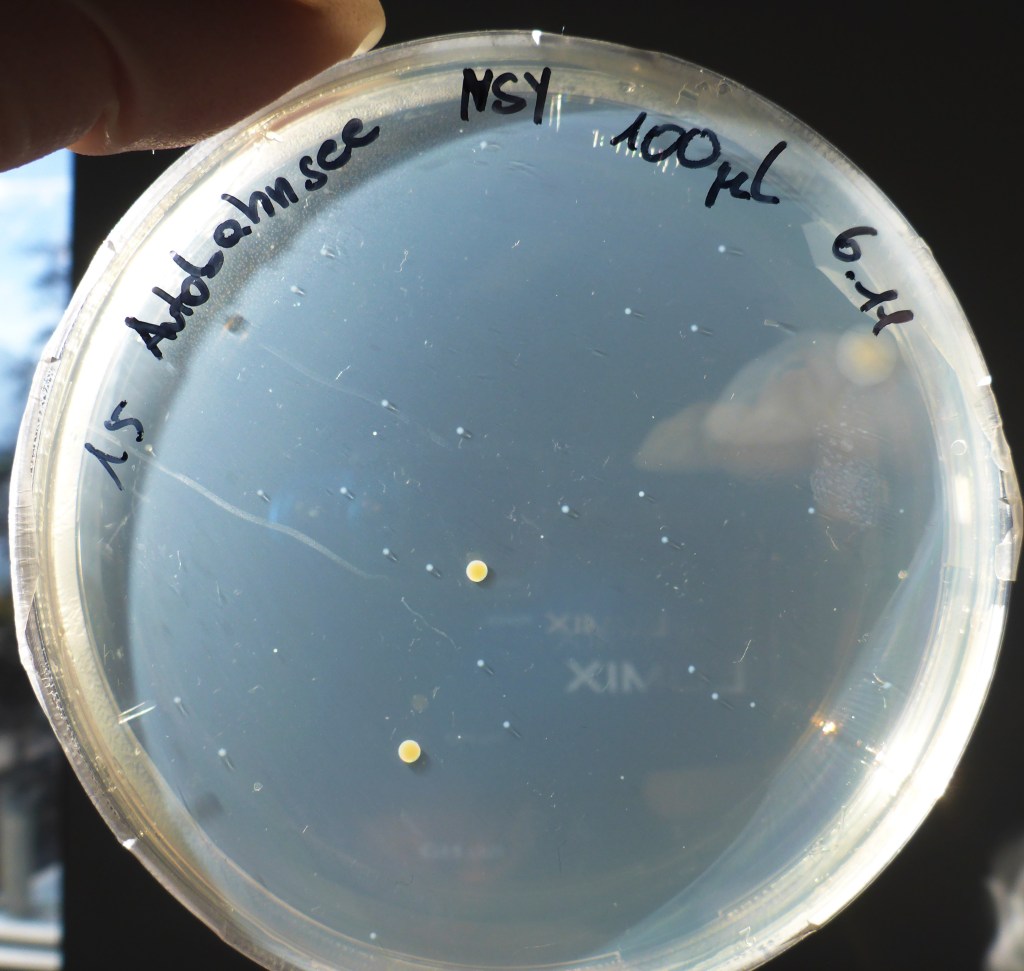
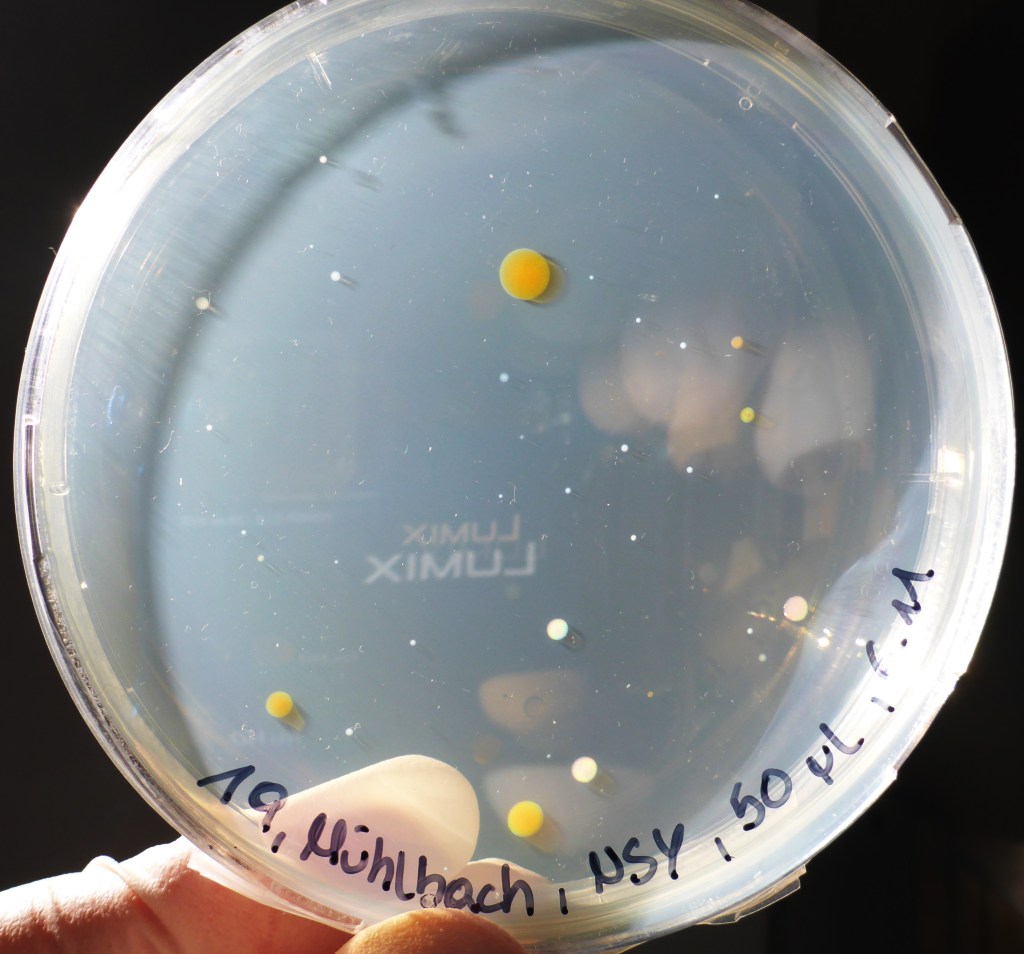
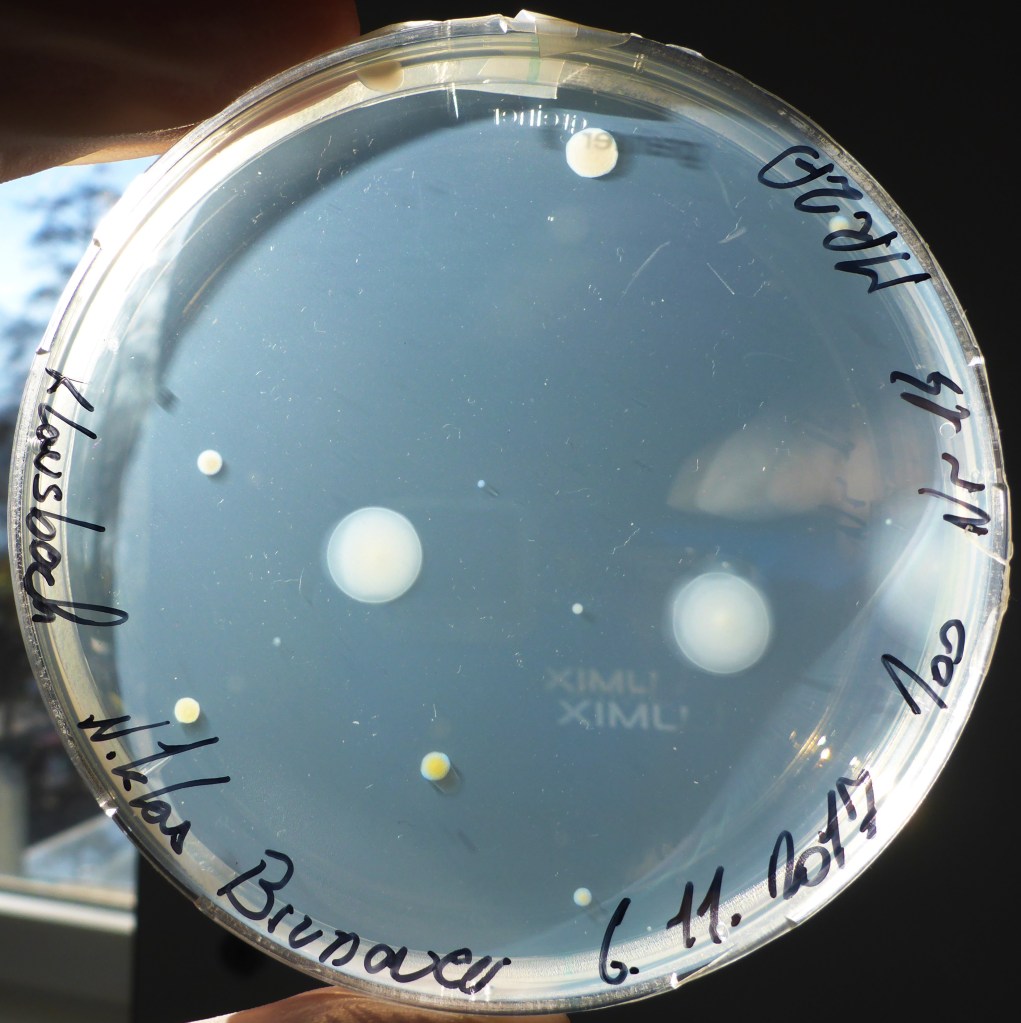
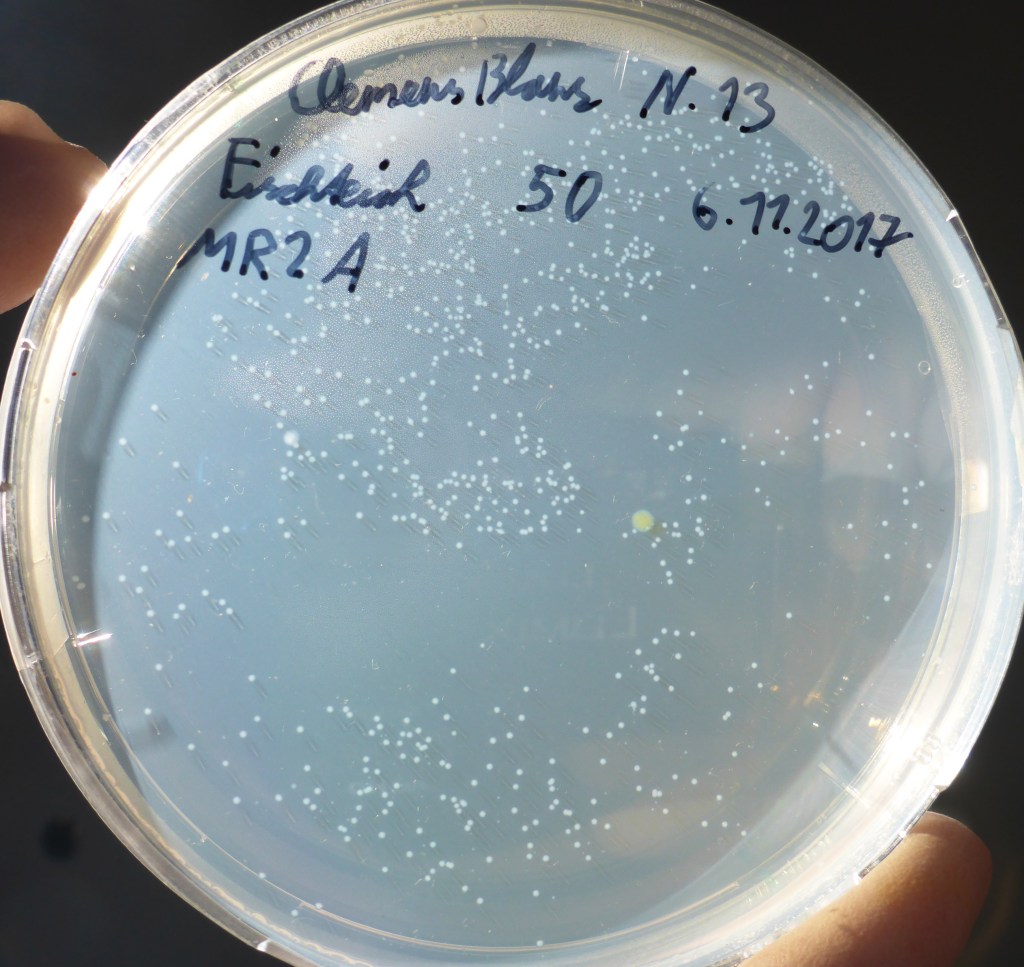
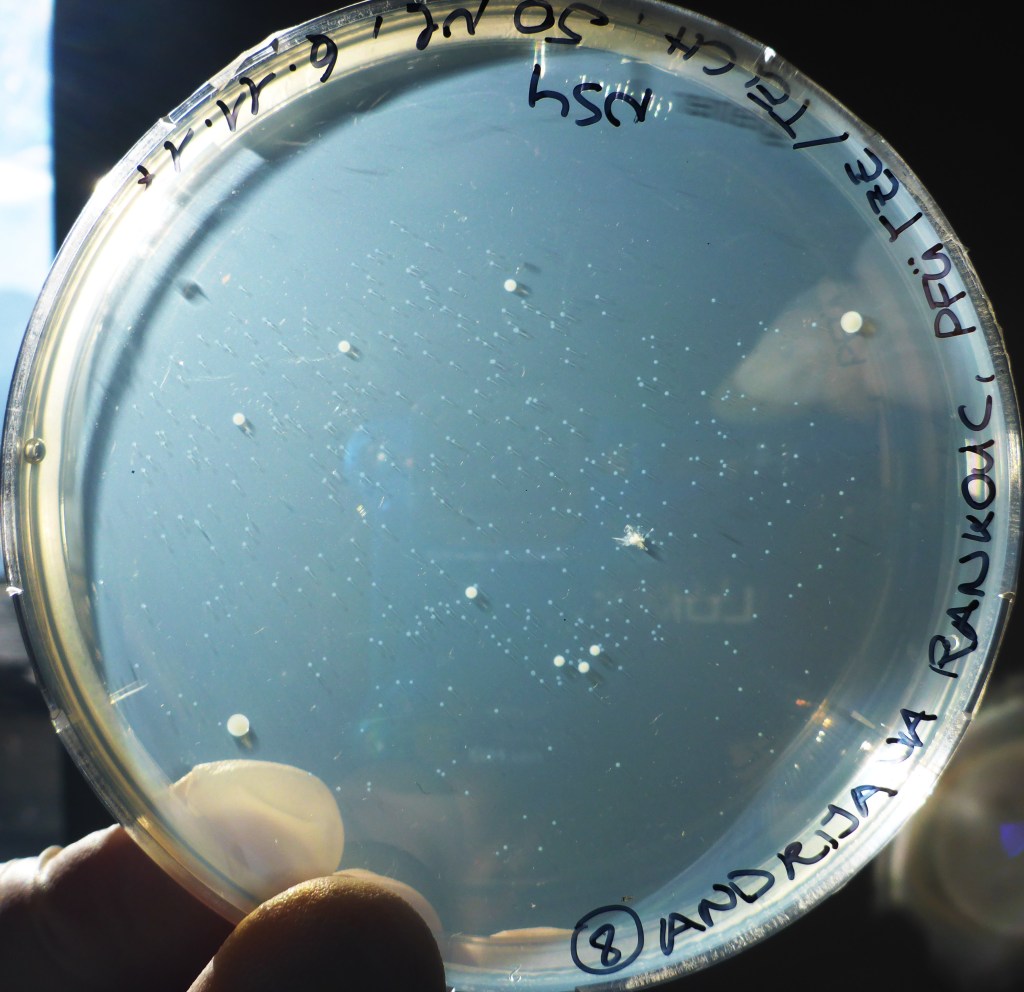
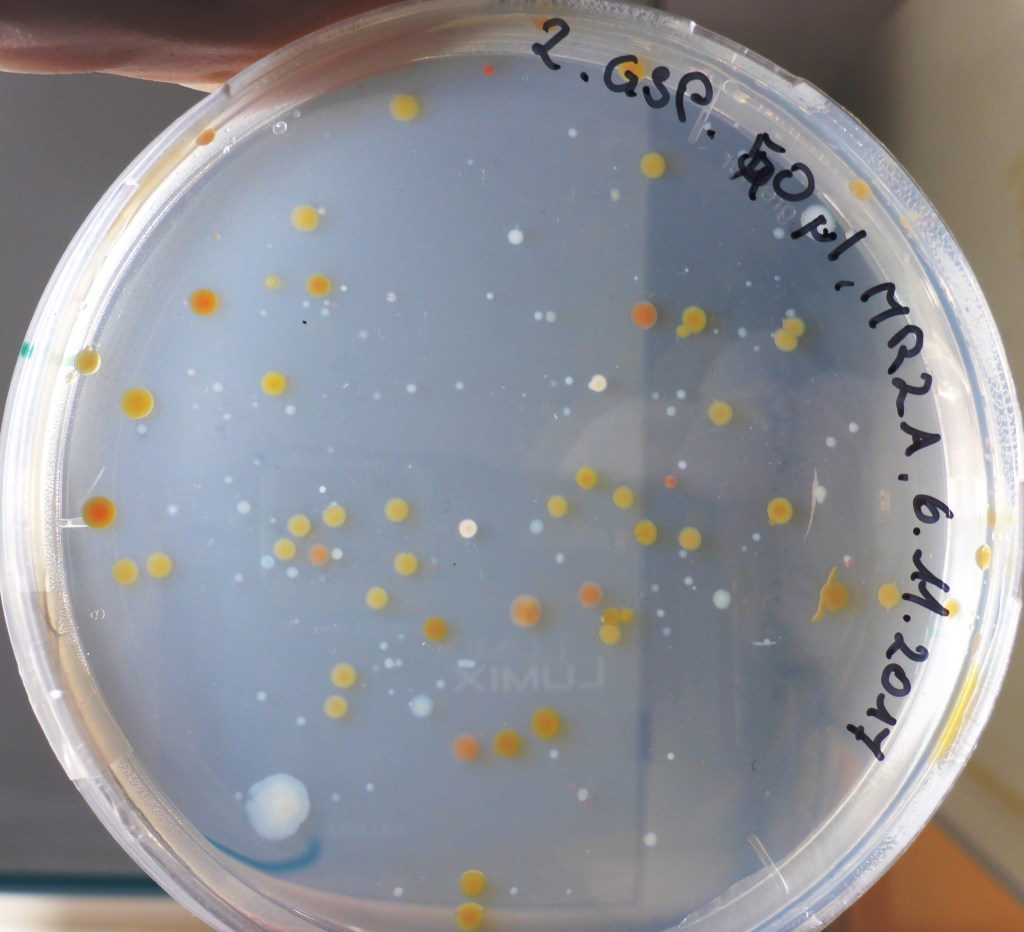
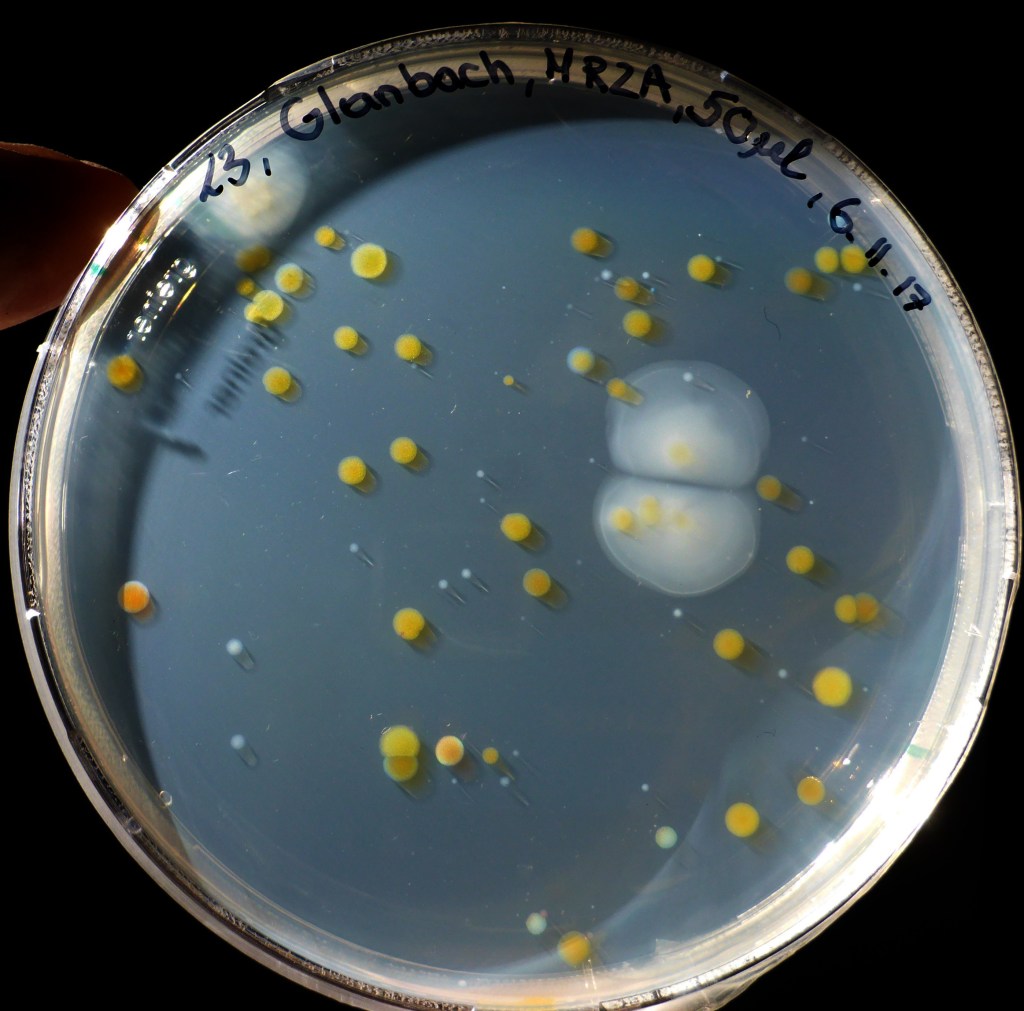
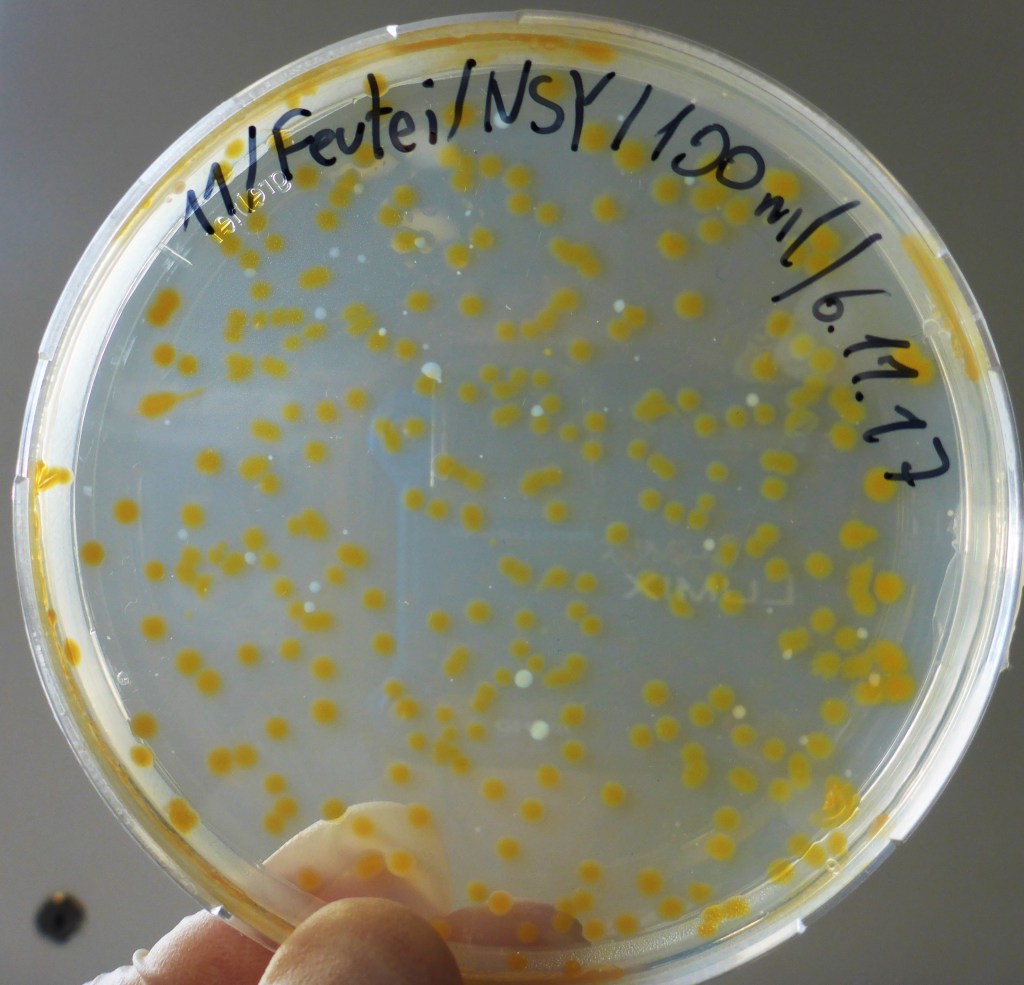
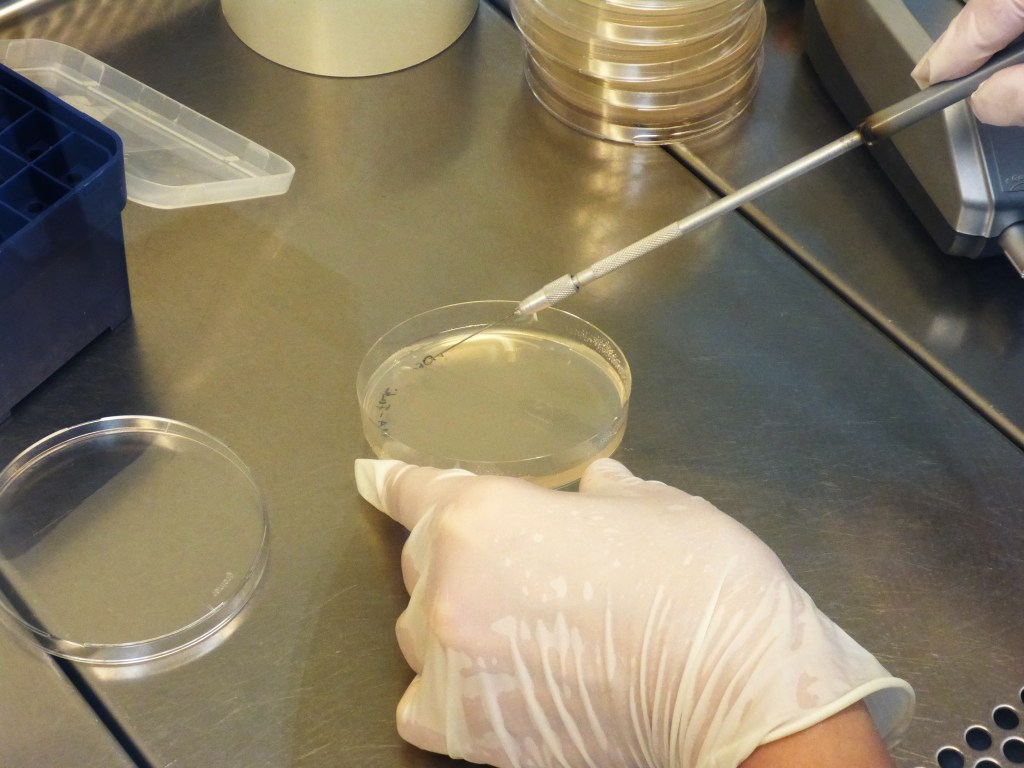

Die im BORG Nonntal von den Schüler/innen der Klasse 6c mit Gewässerproben beimpften Agarplatten wurden 10 Tage bei Raumtemperatur inkubiert. Dann waren schon viele Bakterienkolonien gewachsen:

Unter der sterilen Werkbank wurden einzelne Kolonien mit etwas Agar vorsichtig von der Platte gehoben und in flüssiges Medium gegeben. Als Kulturgefäße dienten Platten mit 24 Vertiefungen und Glaskölbchen (siehe Foto).



Nach einigen Tagen wurden von den Flüssigkulturen die ausgewählt, in denen Bakterien gewachsen waren. Erkennen kann man dies daran, dass das Medium nicht mehr klar wie am Anfang, sondern trüb ist. Es wurden jeweils 50 µl auf eine Agarplatte pipettiert und mit einer Impföse verteilt. Auf diese Weise wurden über 100 Platten mit Bakterienstämmen angelegt.